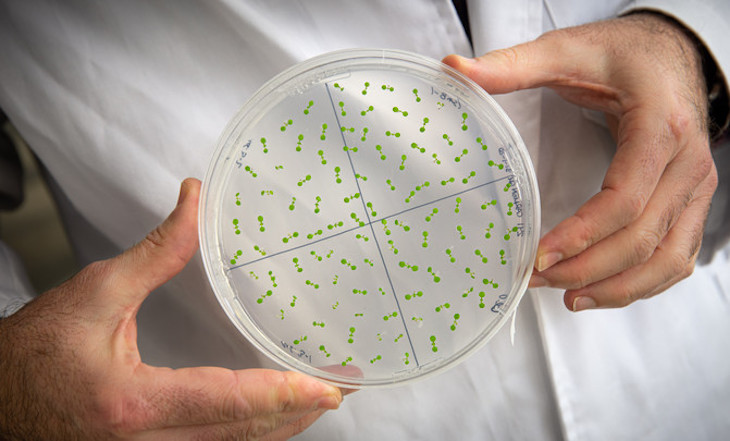

De ello es muy consciente el científico del Centro de Investigaciones Biológicas Margarita Salas (CIB-CSIC) Francisco Javier Medina (Toledo, 1952), que diseñó el primer experimento europeo de biología de plantas en la incipiente Estación Espacial Internacional (EEI) hace 17 años. Lo hizo junto a Roberto Marco, un pionero en este campo fallecido en 2008.
Fue el astronauta español Pedro Duque, actual Ministro de Ciencia e Innovación, el responsable de llevarlo a cabo en octubre de 2003 gracias a la Misión Cervantes.
Aunque estaba previsto para unos meses antes, el proyecto se retrasó por el accidente del transbordador espacial Columbia el 1 febrero de ese año en su reingreso en la atmósfera. Eso dio algo más de margen a Medina y Marco para completar sus experimentos.
“Fue un gran privilegio participar en la misión Cervantes 2003. Una de las contribuciones que España hizo al programa de la Estación Espacial Internacional fue este proyecto de biología de plantas —cuenta Pedro Duque a SINC—.
El equipo del CIB aprovechó muy bien esta oportunidad para adquirir una experiencia valiosa en la preparación de experimentos biológicos en ingravidez, lo que les ha valido para ser ahora referentes y colaborar con investigadores de EE UU”.
Durante sus entrenamientos en la Ciudad de las Estrellas a las afueras de Moscú, el astronauta recibió en agosto de ese año la visita de los científicos que le dieron las instrucciones y el material para realizar los diferentes experimentos, un total de 24 en diez días dentro del programa de la Agencia Espacial Europea (ESA).
Las muestras que trajo Pedro Duque de vuelta a la Tierra —en una caja que sostenía sobre su cabeza debido al limitado espacio de la nave rusa Soyuz— marcaron el inicio de la investigación de los cultivos de plantas para la exploración espacial.
Con estos primeros resultados, en una colaboración de la NASA y la ESA, Medina preparó con el científico estadounidense John Kiss el experimento que dio lugar en 2009 al proyecto Seedling Growth, con el que ambos equipos acaban de recibir el premio NASA Group Achievement.
Este reconocimiento se une a la Medalla ELGRA, concedida al investigador español en el congreso de la Sociedad Europea de Investigación en Microgravedad, celebrado en Granada el pasado mes de septiembre.
Hablamos con Medina en su laboratorio, en Madrid.
Hacer crecer plantas fuera de la Tierra suena un poco a ciencia ficción…
Sí, de hecho, es algo que se plantea en la película Marte, que es buena desde el punto de vista científico. Para cultivar en un planeta como el marciano hay que suministrar una réplica de la atmósfera terrestre y después, complementar los compuestos del suelo con otros, porque el suelo de Marte no es capaz de nutrir a la planta por sí solo. El protagonista de la película lo soluciona con excrementos o estiércol, como un agricultor.
Así que conseguiremos algún día plantar patatas, como Matt Damon, ¿no?
Por supuesto, o cualquier otro vegetal. Lo que necesita el ser humano para vivir en un planeta exterior es energía (la del Sol), agua (en los casquetes de la Luna parece que hay hielo y de él se obtiene oxígeno, por lo que se puede conseguir una réplica de la atmósfera respirable), un habitáculo donde vivir y alimento.
Y eso las plantas lo dan, y de alta calidad, porque tienen vitaminas y otros elementos propios, además de oxígeno, humedad y la capacidad de eliminar el CO2. Las plantas son esenciales en el soporte vital para la exploración espacial del ser humano.
Una cosa que no tuvo en cuenta esta película fue la gravedad, y esto es parte de su investigación. ¿Qué importancia tiene este elemento en el desarrollo de las plantas?
Es uno de los retos más importantes de la exploración espacial. A la hora de ponerse a cultivar plantas en el espacio, hay que proveerlas de una serie de factores medioambientales que se pueden obtener in situ o suministrar desde la Tierra. Pero hay un elemento que es insustituible: la gravedad que dirige su crecimiento.
Crecen con la raíz hacia abajo y con el tallo y las hojas hacia arriba. Los conceptos “abajo” y “arriba” son gravitatorios. Sin ellos, les quitamos a las plantas un elemento esencial para su desarrollo.
La gravedad es el único componente medioambiental que ha permanecido constante tanto en su existencia como en su magnitud desde que la Tierra es Tierra y la vida es vida. En todo nuestro planeta hay gravedad 1 g, sin diferencias significativas entre unos puntos y otros.
¿Cómo reaccionan las plantas ante la ausencia de gravedad o en una gravedad inferior a la de la Tierra?
Las plantas pueden afrontar muchos tipos de estrés, que pueden ser bióticos —causados por otros seres vivos— o abióticos —en condiciones adversas motivadas por factores físicos o químicos medioambientales—.
En la Tierra, la gravedad nunca es un estrés abiótico para ellas porque ha sido siempre constante, pero en el espacio sí. El principal problema es que los esquemas de orientación desaparecen.

¿Qué aspecto tienen esas plantas que crecen sin gravedad?
En las plántulas que crecen en la Estación Espacial Internacional, la raíz y el tallo crecen en direcciones aleatorias, hacia donde quieren. La planta se desorienta completamente. Pones una al lado de la otra y cada una tiene el tallo y la raíz hacia lados distintos.
Claro, pierden sus puntos de referencia…
Eso es, no tienen ninguno. El punto de referencia que es el vector gravedad, que desencadena el gravitropismo (el movimiento orientado según la gravedad), desaparece.
¿Qué daños sufren en esta situación?
Eso fue lo que estudiamos en nuestro primer estudio espacial en la Misión Cervantes en los albores de la construcción de la Estación Espacial Internacional. Encontramos importantes alteraciones celulares.
Como las plantas no se pueden escapar cuando las cosas vienen mal dadas, tienen que prever mecanismos de resistencia ante lo desconocido. Y uno de ellos es la existencia del llamado tejido meristemático, que les permite tener una reserva de células preparadas para especializarse en cualquier función.
Durante toda su vida mantienen una reserva de células indiferenciadas o totipotentes (que valen para cualquier cosa) en la punta de la raíz y en la del tallo, que están continuamente dividiéndose y en un determinado momento pueden especializarse en lo que haga falta. Es un tejido muy importante…
Y lo que les permite sobrevivir, supongo…
Sí, en condiciones normales este tejido provee de células para el desarrollo y crecimiento porque no dejan de proliferar. Están continuamente realizando el ciclo celular, y para eso tiene que haber una estricta coordinación entre el tiempo en que la célula se divide y el tiempo en que está creciendo.

Esa coordinación la deshace la ingravidez y esto pone en riesgo aspectos importantes para su supervivencia.
¿Qué otros aspectos de la planta se alteran en ausencia de gravedad?
Hay un impacto en los balances de reparto hormonal, que sirven para la coordinación de la fisiología de la planta en todos sus órganos, y hay genes que están desregulados, entre otros efectos. Sabiendo todo esto, hemos ido viendo cómo podíamos compensar o contrarrestar estas alteraciones.
¿Y cómo se puede lograr?
A base de suministrar otro tipo de referentes para el crecimiento como la luz. Junto al gravitropismo existe el fototropismo, que es el crecimiento dirigido por la luz.
La cuestión es si la iluminación es capaz de compensar, y en qué medida, los efectos perniciosos de la falta de gravedad. Este ha sido el objetivo del proyecto Seedling Growth que hemos desarrollado estos últimos años junto con un equipo norteamericano y otros grupos europeos.
¿Qué resultados han obtenido con la luz como única referencia de la planta?
Esto ha sido gran parte del trabajo de Raúl Herranz en nuestro laboratorio, como experto en métodos de análisis de la expresión génica. El patrón de expresión génica con luz en el espacio se parece más al patrón con gravedad en la Tierra.
Hemos visto qué genes se expresan en la Tierra en condiciones control, cuáles se expresan sin gravedad y sin luz, y cuáles sin gravedad y con luz.
En ausencia de gravedad sin luz hay unas gravísimas alteraciones del patrón de expresión génica que en gran parte se revierten con presencia de luz.
Pero en el espacio no siempre hay luz, entonces habrá que generar esas condiciones…
En el experimento se utilizó la luz roja porque sabíamos que, además de orientar el crecimiento, es capaz de activar una serie de procesos celulares que se alteran en ausencia de gravedad, como la producción y la activación de proteínas, la proliferación celular, etc.
La luz roja tiene un receptor propio en las células, un fitocromo, que es excitado específica y exclusivamente por esa longitud de onda y activa esos procesos. Así, los genes desregulados sin gravedad vuelven a regularse con iluminación roja.
¿Qué tipo de organismo vegetal viaja al espacio?
Hasta ahora hemos utilizado una especie vegetal modelo: Arabidopsis thaliana. Es parecido al ratón de laboratorio en la investigación biomédica, aunque la de plantas no plantea generalmente problemas bioéticos.
Es una hierba sin interés agronómico, pero sí posee una serie de características que la hacen perfecta para hacer estudios genómicos y obtener mutantes.
Además es muy pequeña, se puede cultivar en grandes extensiones y su ciclo vital es muy corto. Los resultados sobre esta planta pueden ser fácilmente entendidos y reproducidos por otros biólogos vegetales no espaciales.

De hecho, tratamos de que nuestros estudios, en la medida de lo posible, no se publiquen en revistas de espacio, sino de biología.
¿Se investigará sobre otras especies?
Sí, ya estamos en la fase de saltar del modelo a la planta de cosecha. Ya se ha probado a cultivar lechugas y coles. Justo en este momento estamos definiendo con las agencias espaciales el nuevo modelo vegetal sobre el que trabajar y seguramente no sea único.
El problema es que hay una gran diversidad de plantas.
Una vez que logremos construir bases lunares o marcianas, ¿las plantas podrán proporcionarnos los mismos elementos que aquí en la Tierra?
Estamos convencidos de que sí. No se puede responder al 100 % pero en principio nada hace pensar que las plantas crecidas en el espacio vayan a ser distintas de las de la Tierra.
Estamos tratando de conseguir que las plantas que han crecido mal en condiciones espaciales crezcan bien, como en nuestro planeta. El objetivo es que aporten al explorador espacial lo mismo que al habitante de la Tierra.
¿Cómo se desarrolla y monitoriza un experimento espacial, sabiendo que todos los científicos estáis en tierra?
La experimentación espacial nos cambia muchos esquemas. El tipo de requerimientos (dinero y medios) e inconvenientes no son habituales.
Si uno hace un experimento aquí en el laboratorio y le sale mal, pues lo repite al día siguiente. Como salga mal el experimento espacial, a lo mejor no se puede repetir nunca porque los recursos disponibles en la estación espacial son limitados y eso condiciona las convocatorias y la preparación. En el mejor de los casos se puede repetir cuatro o cinco años después.
Por otra parte, cuando uno trabaja en el laboratorio todo el mundo implicado en el experimento es experto. Para eso estamos los científicos. Pero en el espacio no.
Allí hay un astronauta que tiene que hacer un experimento de física, otro de biología humana, otro de plantas y otro de observación de la Tierra.
La EEI ha sido un avance impresionante en la capacidad de experimentación. Puede considerarse, aunque aún no lo es del todo, algo parecido a un buen centro de investigación multidisciplinar. Todo esto cuesta un dineral, que es una acusación que nos hace la comunidad científica.
¿Y cómo responden a esas acusaciones?
Bueno, uno puede especular con un montón de objetivos futuros que pueda tener la humanidad con la exploración espacial, pero lo cierto es que es un anhelo del ser humano. Yo no digo que lo que yo estoy haciendo sea lo más importante para la humanidad, ni muchísimo menos. Pero lo que hago puede interesar a mucha gente.
El tipo de experimentación en la EEI contribuye además a que los grupos de investigación de diferentes países se unan. ¿Son muchas personas al final?
Sí, nos juntamos y nos comunicamos, pero no somos tantos. La masa crítica internacional de científicos dedicados a estos temas, sobre todo en Europa, es una de nuestras quejas. Somos pocos, deberíamos ser más. A lo mejor es que no hay incentivos suficientes por parte de la ESA.
Ahora que se están reanudando misiones espaciales, ¿no cree que existe una posibilidad de que eso cambie?
Por supuesto. En estos días, el CSIC está definiendo objetivos para el horizonte 2050 y la exploración espacial es uno de ellos. Varios grupos de biología de plantas han mostrado interés en este tema, aun sin tener experiencia directa en biología espacial.
Les ha interesado la posibilidad de poner las plantas en condiciones extremas e investigar las consecuencias de ello, así que bienvenidos al club. Ahora podremos ser más. Es muy importante diversificar los temas de investigación.
La exploración espacial no solo nos cuenta lo que pasa en el espacio, también nos da información sobre nuestro planeta. ¿Cómo se traduce eso en las plantas de la Tierra?
Sabemos más sobre los mecanismos de defensa de las plantas frente a los estreses. Es un mundo sin fin. Sorprende la enorme plasticidad del genoma de las plantas y de su fisiología para sobrevivir en ambientes desconocidos e insospechados.
Esa es la gran lección que nos da la investigación en biología espacial de plantas. Hasta ahora, muchos grupos, sobre todo con el cambio climático, analizaban el estrés abiótico y su capacidad de supervivencia.
Poner a las plantas en ausencia de gravedad abre un mundo nuevo. Hay plantas que viven en el desierto, en la Antártida, pero también las hay que lo hacen en ausencia de gravedad. Y habrá plantas que vivan en la Luna.
Con algo de ayuda…
Claro, no se podrán tirar semillas en la superficie lunar y esperar a que crezcan. Habrá que crear las condiciones adecuadas en un invernadero.
¿Cuándo cree que esto será posible?
Bien pronto. En 2024, la astronauta estadounidense que pise de nuevo la Luna seguramente lleve con ella —si no es en la primera misión, será en alguna de las primeras— un pequeño invernadero.
En ese momento estará la nueva estación espacial que orbitará de manera permanente la Luna, la llamada Gateway, donde se ha implicado activamente la ESA.
Desde allí irán y volverán misiones concretas a la superficie lunar con astronautas. Muy pronto uno de ellos llevará una instalación con plantas.
¿Quién está desarrollando esos invernaderos?
En este sentido, hay que reconocer los esfuerzos de la NASA. Yo desde Europa me quejo, ya que con la ESA podríamos haber estado ahora mismo en una situación de liderazgo mundial y estamos en una regular, nada más.
La ESA se ha dormido un poco en estos últimos años, mientras que la NASA ha desarrollado un pack de invernaderos ad hoc en la EEI impresionantes.
El primero, Veg-01, dio lugar a la lechuga que pudieron comerse los astronautas hace unos años, y el otro, el Advanced Plant Habitat, que es una maravilla de invernadero espacial.
¿En qué punto de la investigación se encuentran ahora?
Los análisis de expresión génica que ha realizado Raúl Herranz con otros miembros de nuestro laboratorio y nuestros colegas norteamericanos han mostrado que hay diferentes mecanismos genéticos que no están afectados con la misma intensidad.
Nos acaban de publicar dos artículos en los que hemos probado con gravedades intermedias, no solo la microgravedad, sino también la de Marte o la Luna.
No todos los organismos se recuperan de la misma manera con la luz. Ahora estamos intentando desenmarañar toda esta red de genes y viendo qué funciones de la planta están afectadas y cómo interaccionan entre ellas.
¿Cómo habéis podido trabajar con distintas gravedades?
En la cámara de cultivo de la EEI hemos utilizado un dispositivo con una centrífuga que nos proporcionaba la gravedad que nosotros queríamos.
En principio, esta centrífuga sirvió para realizar un experimento control en el espacio, pero en gravedad terrestre, para ver el efecto de aspectos distintos de la gravedad, como la radiación, y compararlo con el experimento control de referencia en tierra.
Esa centrífuga también la hicimos rotar a la gravedad de la Luna o la de Marte, con lo que pudimos obtener unos resultados muy interesantes con gravedad parcial.
Hemos sido los primeros en probar un aparato desarrollado en el Centro Europeo de Investigación y Tecnología Espacial (ESTEC) de la ESA en Holanda para producir la simulación de la gravedad lunar y marciana.
¿Cómo influyen estas gravedades en las plantas?
La gravedad de la Luna (0,17 g) produce efectos muy similares a la microgravedad, es decir, que las plantas tienen mucha dificultad para orientar su crecimiento y el patrón de expresión génica obtenido se parece mucho.
Por el contrario, con la gravedad de Marte las plantas son capaces de percibir los 0,38 g. Por lo tanto hay gravitropismo en Marte.
Eso es un gran avance…
Sí, bueno, hay muchas otras cosas que solucionar para poder cultivar plantas en Marte, pero la gravedad no parece que vaya a ser un problema de gran magnitud para conseguirlo.

Aunque la gravedad no es igual que la de la Tierra, tenemos fotos de las plántulas crecidas a 0,3 g y no se distinguen de las plantas crecidas en 1 g, la de la Tierra. Tienen su raíz creciendo hacia abajo y sus tallos creciendo hacia arriba.
¿Cuál es el siguiente paso?
Tenemos que comprender cómo vencen ese estrés gravitatorio y cómo funcionan esos mecanismos de percepción de la gravedad parcial.
Conocemos el final de la historia —las plantas se adaptan y sobreviven— pero nos falta por escribir la historia completa desde el principio, aunque ya hayamos hecho el spoiler. Es imprescindible porque tenemos que ser capaces de reproducirlo.
Ahora que ha comprobado la capacidad de supervivencia de plantas en ambientes extremos como el espacio, ¿cree que sería posible encontrarlas en nuestra búsqueda de vida extraterrestre?
No sabemos nada concreto. Yo sé cómo poner seres vivos en el espacio, pero no soy experto en la búsqueda de vida autóctona del espacio. Conocemos la vida que hay en nuestro planeta, pero no otras.
Podríamos especular todo lo que queramos. Ahora estamos empezando una colaboración con un grupo del Centro de Astrobiología del CSIC que trabaja con líquenes en ambientes extremos como la Antártida e incluso el espacio exterior. Resulta que el liquen no se muere, es capaz de acomodarse.

Los estudios con estos modelos tratan de identificar las características que tendría una posible vida desarrollada en ambientes extraterrestres. Y, curiosamente, los efectos de la ausencia de gravedad sobre estos organismos no se han investigado. Eso es justamente lo que vamos a hacer nosotros ahora.
Fuente: Agencia Sinc












